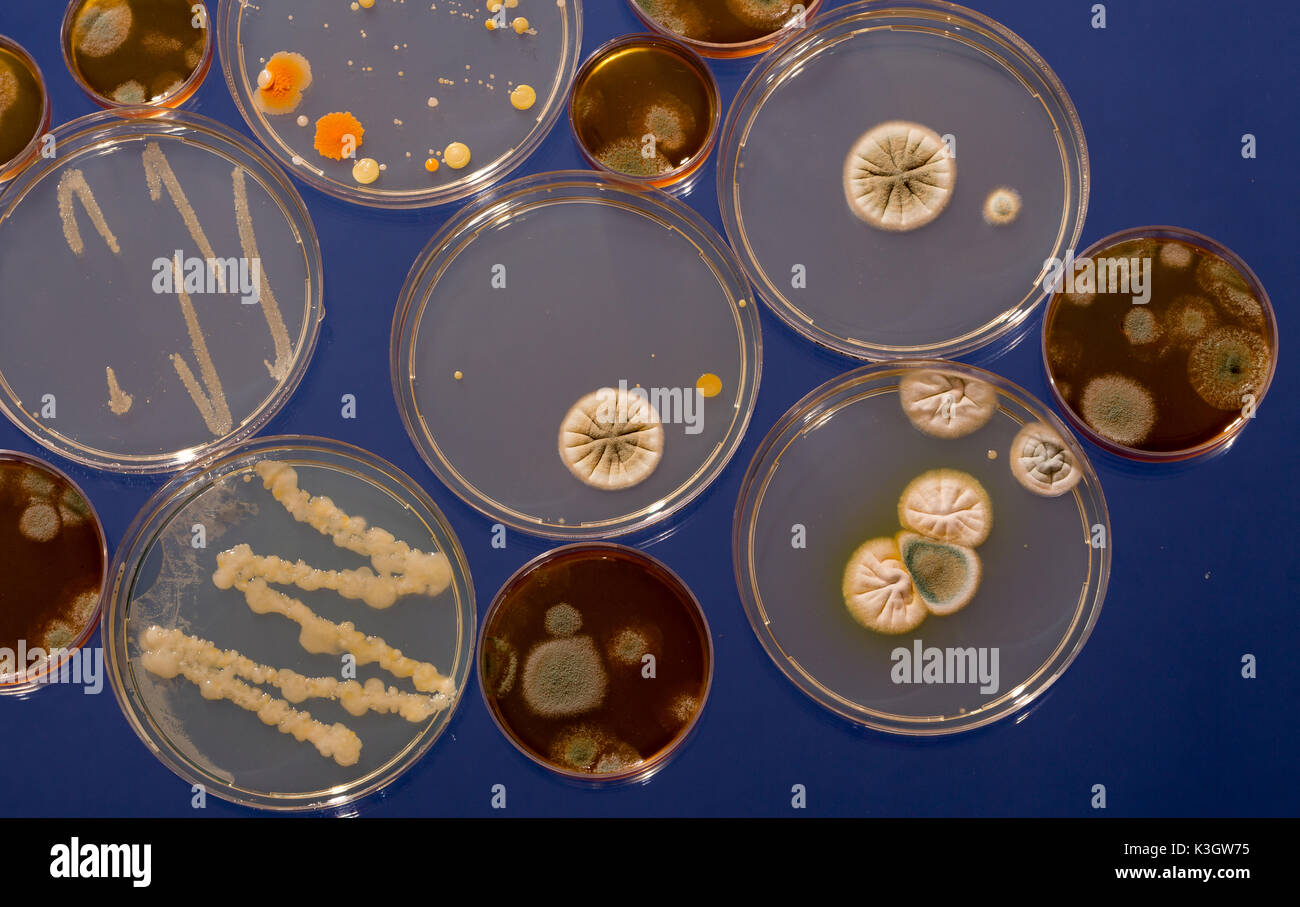
5 Piastre Petri In Vetro Borosilicato 100mm - Per Colture Da Laboratorio, Resistenza Fino A 400°C - Foto 2

5 Piastre Petri In Vetro Borosilicato 100mm - Per Colture Da Laboratorio, Resistenza Fino A 400°C
Disponibile
Disponibile
€ 15
AGGIUNGI AL CARRELLO
Consegna
- Corriere espressoda giovedì 5 febbraioGRATIS
Venduto e spedito da ePRICE

Altri 16 venditori a partire da € 16
- Informazioni legali
- Ne hai uno da vendere?
- 471505
- 86007999555
Pensati per Te
Prodotti simili
Descrizione
Set di 5 piastre Petri in vetro borosilicato, perfette per laboratori o appassionati di scienza! Diametro 100mm, con coperchio inclusi. Resistono fino a 400°C, sono anti-corrosione e riutilizzabili (molto più ecologiche delle versioni in plastica). Ideali per colture cellulari, microbiche o vegetali. Spessore 2mm, trasmissione luminosa ottimale. Imballate con cura per evitare rotture durante la spedizione. Un must per esperimenti seri!Caratteristiche e scheda tecnica
Caratteristiche principali
- EAN7310209774187
Recensioni
2026-02-04 | ahrgamo